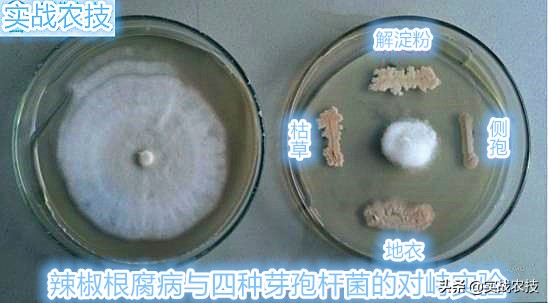
微生物菌剂的意义,冲施微生物菌剂的作用

现在微生物菌剂已经被广泛使用,但是市场上鱼龙混杂质量参差不齐,各种贴牌产品泛滥。优质的有益菌可以起到显著的以菌抑菌、抗重茬、改良土壤、养根护根、促进作物生长、降解农药残留。
通过以菌抑菌实验可以非常直观的看到效果。(看图)
辣椒根腐病与四种芽孢杆菌的对峙实验第三天
左侧培养皿中是辣椒根腐病病菌孢子三天后的繁殖情况,右侧分别是枯草芽孢杆菌、解淀粉芽孢杆菌、侧孢芽孢杆菌、地衣芽孢杆菌,中间是辣椒根腐病病菌孢子。可以直观的看到四种芽孢杆菌都有显著的抑制根腐病病菌孢子的繁殖。

辣椒根腐病与四种芽孢杆菌的对峙实验第七天

辣椒根腐病与四种芽孢杆菌的对峙实验第十天
通过观察第七天和第十天的以菌抑菌对峙实验,可以发现枯草芽孢杆菌和解淀粉芽孢杆菌具有显著的抑制有害菌繁殖的效果。左侧对照培养皿的有害菌繁殖已经打到顶峰占据了整个培养皿。侧孢芽孢杆菌可以活化土壤中被固定的磷、钙等中微量元素,地衣芽孢杆菌诱导植物产生抗病抗逆能力,促进植物生长。

西红柿使用菌剂区域和没有使用菌剂的对比
在实际应用中可以可以更直观的看出,使用菌剂的和没有使用菌剂的西红柿长势要更好更显著。没有使用菌剂的区域有死棵现象,并且整体长势要比使用菌剂区域明显要弱。
总结:使用优质的微生物菌剂可以显著抑制土壤中的有害菌、活化土壤中被固定的矿物质元素磷、钙等中微量元素、改良土壤、增加土壤透气性,有益菌可以代谢出赤霉素、细胞分裂素、吲哚乙酸等促进植物生长,显著提高植物的叶绿素含量、促进植物的根系生长、提高植物抗病抗逆能力、改善果实品质等作用。